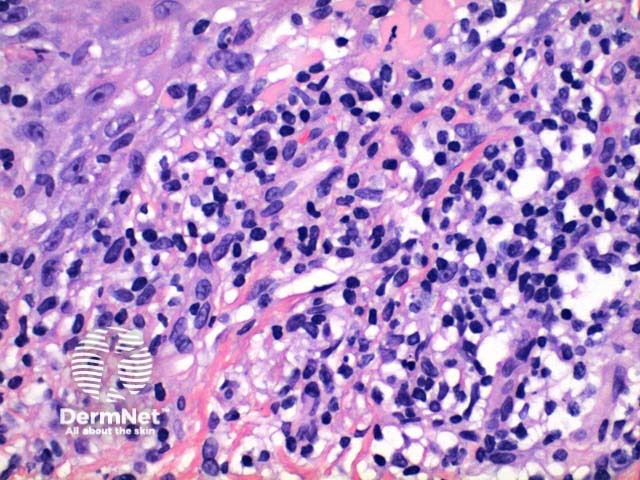
Figure 4

Main menu
Common skin conditions
NEWS
Join DermNet PRO
Read more
Quick links
Autoimmune/autoinflammatory Diagnosis and testing
Author: Dr Ben Tallon, Dermatologist/Dermatopathologist, Tauranga, New Zealand, 2012.
Scanning power view of lichen planus shows a lichenoid reaction pattern (Figure 1) characterised by the combination of degeneration of the basal layer of the epidermis and a band like lymphocytic infiltrate obscuring the dermoepidermal junction. There is irregular epidermal hyperplasia forming a characteristic saw-tooth appearance with wedge-shaped hypergranulosis (Figures 1 and 2). The basal layer of the epidermis exhibits vacuolar degeneration with typically prominent necrosis of individual keratinocytes (Figure 3). The inflammatory infiltrate is chiefly lymphocytic and forms a dense band in the superficial dermis (Figure 4).

Figure 1

Figure 2

Figure 3
Figure 4
On direct immunofluorescence in lichen planus, shaggy linear basement membrane and colloid body staining can be seen with fibrinogen.
Lichenoid keratosis: The histologic findings of lichenoid keratosis (also called lichen planus-like keratosis) are largely not discriminatory, with distinction relying on the clinical setting. The presence of parakeratosis and an infiltrate containing increased numbers of eosinophils and neutrophils may distinguish this lesion from typical lichen planus. While an increased number of Langerhans cells are seen in lichen planus, an absolute number is not able to discriminate between these entities.
Keratosis lichenoides chronica: In addition to also containing numerous necrotic keratinocytes the epidermis of keratosis lichenoides chronical shows parakeratosis containing neutrophils. Clinical correlation is essential.